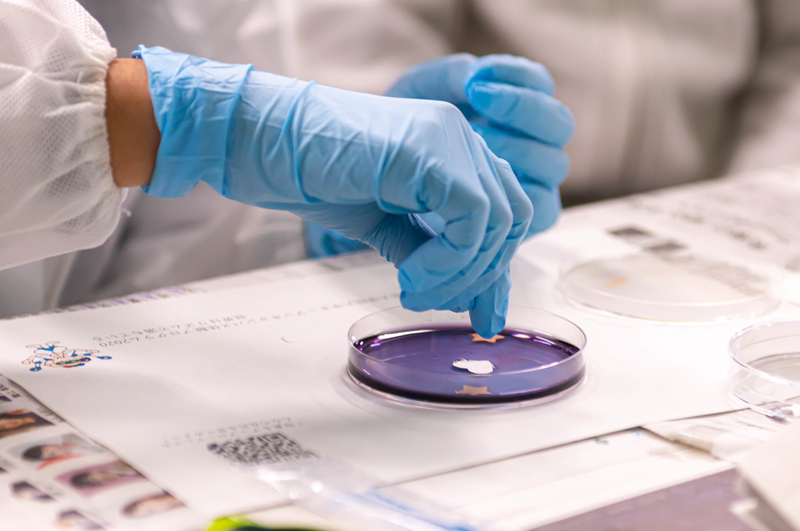
オープンキャンパス2020を開催（2020/11/15）

11月15日(日)に、「オープンキャンパス2020」を開催しました。
このオープンキャンパスは、大学の施設や研究室を開放し、本学の研究成果を子どもから大人まで広く地域の皆さまに分かりやすく紹介するとともに、本学の魅力をアピールすることを目的に開催している恒例の行事です。
今年は、新型コロナウイルス感染症の感染拡大防止の観点から、現地開催型のオープンキャンパスと、オンライン型のバーチャルオープンキャンパスを同時開催いたしました。
今回で26回目の開催となる現地開催型のオープンキャンパスは、例年よりも規模を縮小し、同感染症の感染拡大防止対策について万全に配慮したうえで開催いたしました。当日は事前申込された方々369名が本学を訪れ、3つの「体験プログラム」のほか、各領域でのパネル展示や、学生の課外活動団体によるイベントなど最先端の科学技術に触れ親しみました。
そのほか、受験生向けのプログラムとして入試説明会、学生宿舎見学も実施しました。
また、バーチャルオープンキャンパスでは、学内バーチャルツアー、研究室紹介、オンラインパネル展示、体験プログラムの紹介動画等を用意することで、当日参加できなかった方々も、自宅から楽しんでいただける催しとしました。
来場者には、本学で行われている研究を通じて科学の魅力を身近に感じてもらうとともに、未来の科学者達に夢を持ってもらえるよう親子・友達で楽しむプログラムやデモを実施した本イベントは、今回も大盛況のうちに幕を閉じました。